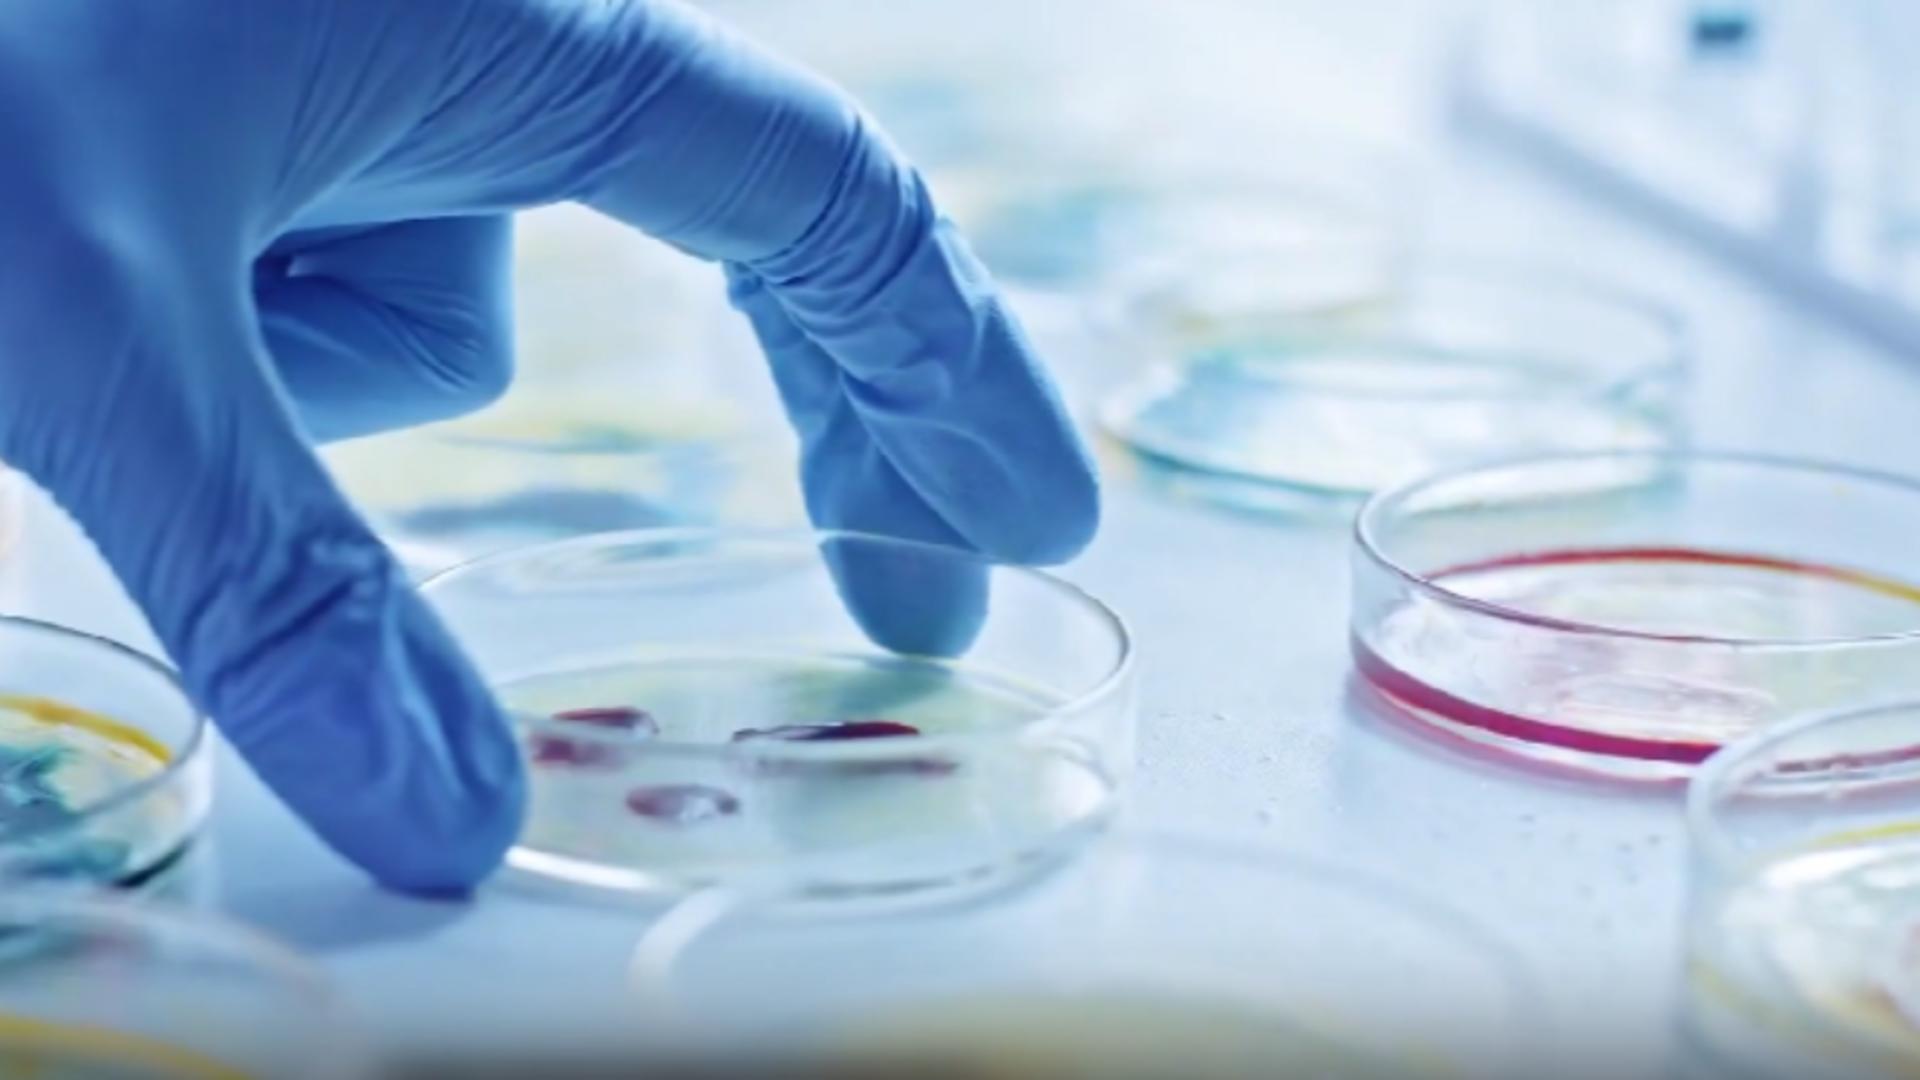

Este vorba despre un medicament folosit pentru a trata boli cronice de plămâni. Procesul de cercetare a capsulei a început în anul 2020, cu scopul de a găsi un leac la afecțiunea pentru care existau doar medicamente ce puteau numai să încetinească progresul bolii, nu să și trateze cauza.
Acum, prima fază a testelor se derulează în China, pe parcursul a 12 săptămâni. Apoi, testările se vor face și în SUA unde se va ajunge la 60 de testări din 40 de orașe.
Compania a primit până acum finanțări de peste 400 de milioane de dolari pentru a pune în aplicare inovația.